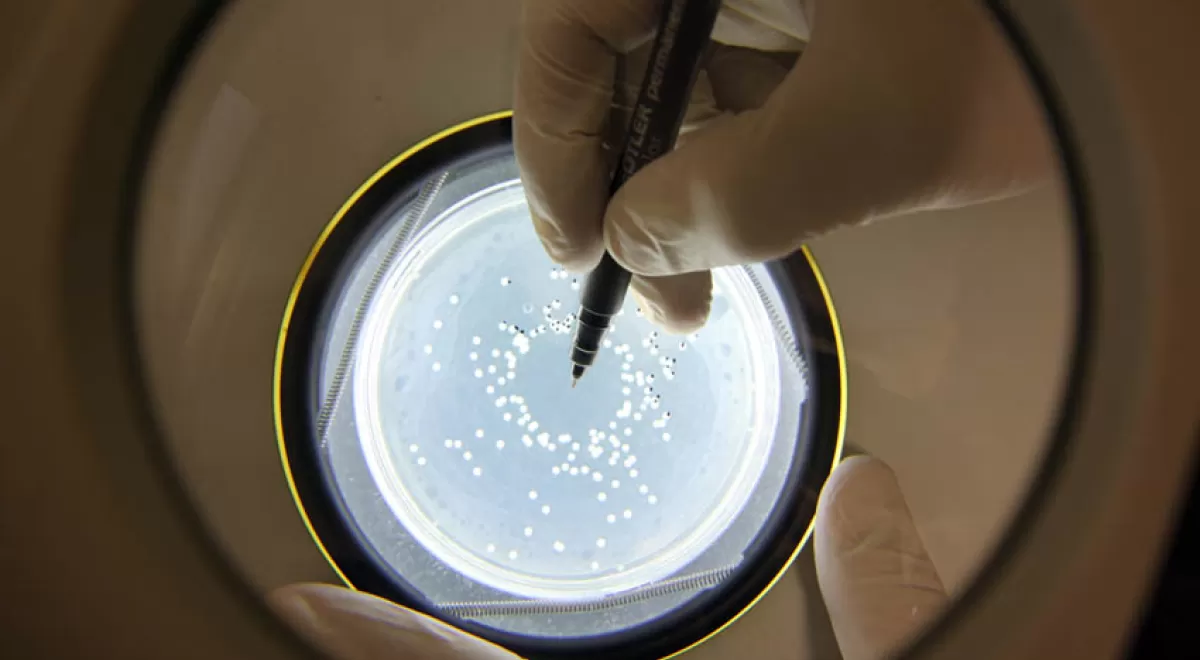

ITENE aportará nuevas técnicas para aprovechar residuos biodegradables
- 1738 lecturas
- 1738 lecturas
El Instituto Tecnológico del Embalaje, Transporte y Logística (ITENE) aportará nuevas técnicas para aprovechar y valorizar residuos biodegradables para reintroducirlos en el ciclo productivo con un enfoque de economía circular mediante el proyecto BIOSUST, en el que se trabajará tanto con papel y cartón como con las fracciones orgánicas de los residuos de origen urbano.
Esta iniciativa, actualmente en desarrollo y que cuenta con financiación del Instituto Valenciano de Competitividad Empresarial (IVACE) a través del Fondo Europeo de Desarrollo Regional (FEDER), permitirá plantear nuevas técnicas de descontaminación de papel y cartón, mejoras en las técnicas de compostaje y nuevos procesos de hidrólisis y fermentación, esto último para aprovechar al máximo la materia orgánica contenida en los residuos de origen municipal.
Por un lado, ITENE centrará sus esfuerzos en el desarrollo de técnicas de descontaminación para eliminar de las pastas papeleras aquellos contaminantes que restringen su uso para aplicaciones de contacto alimentario (aceites minerales saturados -MOSH- y aceites minerales aromáticos -MOAH-, y otras sustancias críticas).
Por otra parte, se introducirán mejoras en las técnicas de compostaje industrial con el fin de obtener un compost de mayor calidad en menos tiempo. En este ámbito, optimizarán estos procesos mediante la adaptación de diversos parámetros y el uso de poblaciones microbianas seleccionadas para obtener abonos de mayor calidad. Además, se trabajará en el desarrollo de modelos matemáticos para predecir y por tanto optimizar los procesos de compostaje, tanto a nivel industrial como en laboratorio.
Además, con el objetivo de mejorar los procesos de pruebas de compostabilidad, se desarrollará una tecnología propia para el micronizado de materia orgánica de forma efectiva y optimizada. El micronizado consiste en pulverizar un material sólido hasta que sus partículas alcancen el tamaño de micrómetros. Estos desarrollos se centrarán en la materia orgánica recogida selectivamente en la Comunitat Valenciana (contenedor marrón).
Por último, para conseguir el máximo aprovechamiento de la materia orgánica contendida en los residuos de origen municipal se trabajará en la monitorización de la degradación de la materia orgánica a través de sensores para evitar que se transformen en productos químicos no aprovechables.
Además, ITENE desarrollará nuevos procesos de hidrólisis (reacción química en la que el agua actúa sobre otra sustancia para formar una o más sustancias nuevas) y de fermentación para adecuar las propiedades de los residuos orgánicos y garantizar su posterior aprovechamiento en aplicaciones de alto valor añadido (precursores, productos técnicos, polímeros, alcoholes, etc.).
Esta tecnología permitirá obtener valor de los residuos orgánicos urbanos recogidos tanto de la recogida en masa (contenedor gris) como de los nuevos sistemas de recogida selectiva de orgánico (contenedor marrón).
















